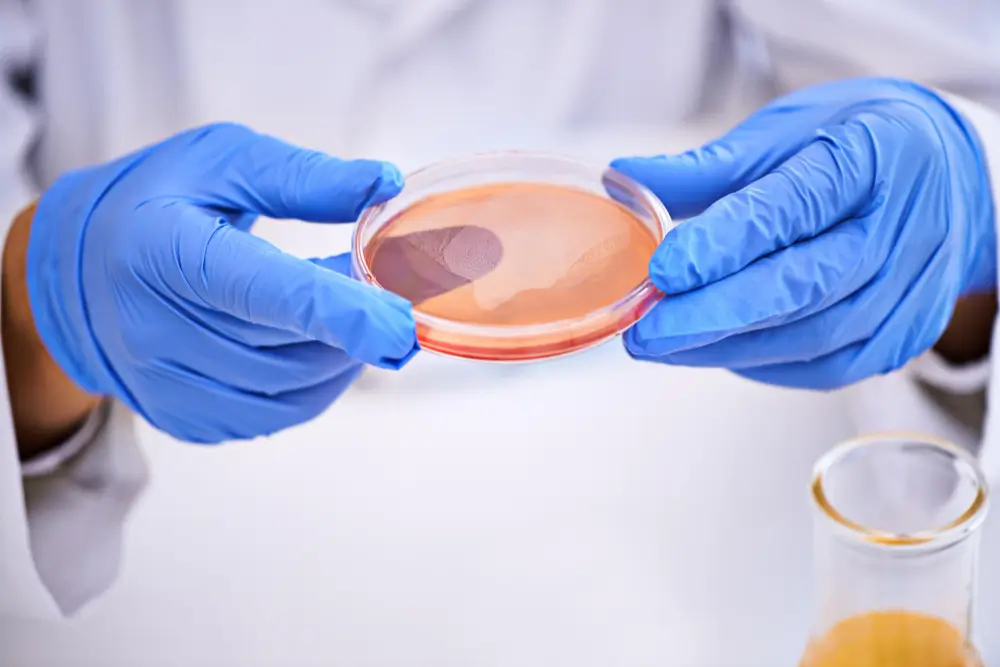
IVF

How to Choose a Surrogacy Agency: What Intended Parents Should Know Before Signing

AI Smart Summary Box (Fast Facts) Best For: Intended parents considering surrogacy before signing an agreement What a Surrogacy Agency Does: Screens and matches surrogates (and egg donors if needed) Coordinates IVF clinics and medical timelines Manages legal contracts and parentage protection Provides case management and emotional support Key Factors to Evaluate: Experience and proven […]
Egg Donor Eligibility Criteria to Be A Frozen Egg Donor

Becoming a frozen egg donor is a deeply meaningful way to help individuals and couples build their families through assisted reproductive technologies like IVF. Since this process involves ovarian stimulation, egg retrieval, and the long-term preservation of oocytes, egg donor clinics follow strict requirements for egg donation to protect donor health and ensure the best […]
Understanding The Differences Between Standard IVF And Egg Donation IVF
AI SUMMARY BOX FAST FACTS Services IVF Coordination, Egg Donation, Fertility Consultation, Genetic Testing, IVF with Egg Donor, Egg Freezing Availability IVF and egg donation services are available in leading fertility clinics worldwide, including the U.S., Europe, and Asia Average Total Cost Standard IVF: $10,000 – $15,000 USD per cycle Egg Donation IVF: $15,000 – […]
Beautiful Egg Donors and IVF: Smart Choices for Intended Parents

For many aspiring parents, the decision to use donor eggs in conjunction with IVF is a significant and emotional one. You’re not just selecting a medical procedure, but also choosing an egg donor whose attributes, health, and experience will play a meaningful role in your journey. With services like EggDonors4All guiding intended parents, the process […]
IVF or IUI: Choosing the Right Fertility Treatment for You

When faced with fertility challenges, deciding between treatment options can be overwhelming. Two of the most common routes in reproductive medicine are Intrauterine Insemination (IUI) and In Vitro Fertilization (IVF). While both share the same goal — helping you conceive — they differ in complexity, invasiveness, cost, and suitability depending on your fertility profile. At […]
Why Families Are Searching for Beautiful Egg Donors Today

In recent years, there’s been a noticeable rise in intended parents searching for beautiful egg donors. While beauty may sound like a superficial preference, the truth is that most families today are seeking more than just physical appearance — they’re looking for donors whose inner and outer qualities reflect intelligence, kindness, health and balance. The […]
Navigating the Emotional Waves When You Choose to Become an Egg Donor

Choosing to become an egg donor is a deeply personal and life-changing decision. It’s an act of compassion that helps others experience the joy of parenthood — something many people dream about but cannot achieve on their own. While the process involves medical steps and careful screening, what often goes unspoken are the emotions that […]
200 Best Top Egg Donor Agencies in the USA – Here Are the Top Performers of 2025
Your 2025 Guide to Choosing a U.S. Egg Donor Agency Embarking on the journey of starting a family through egg donation is an act of hope that requires careful, informed decision-making. Selecting the right agency is arguably the most critical step—it is the foundation of your process, built on principles of trust, clinical safety, and […]
Egg Donation: How Much Does Location Matter for Donors?

If you’re considering becoming an egg donor, you might wonder whether your location plays a significant role in the process. The answer is nuanced and depends on various factors, including the policies of the egg donation agency, the fertility clinic’s requirements, and logistical considerations. Many women interested in egg donation New York often ask whether […]
Freeze Your Eggs: What To Expect From Matching & Screening

Nowadays, more and more women are claiming their rightful role as the commodore of their reproductive ship, and one of the trendier options that has been culturally on the increase is to freeze their eggs. If you’re career-developing, looking for that person, or just not quite at a parent-oriented point, egg freezing just keeps you […]